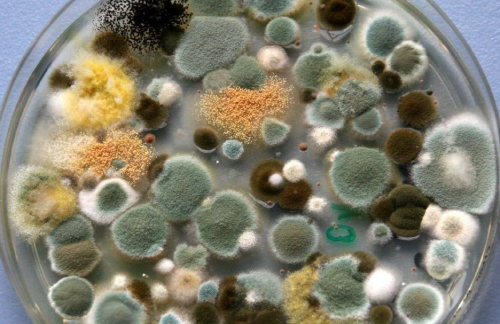
鲸立迷你洗衣机怎么样?分享五款最实用的迷你洗衣机品牌!

在快节奏的现代生活里,洗衣这件日常小事也暗藏烦恼。内衣、宝宝衣物,担心与其他衣物混洗不卫生。迷你洗衣机的出现,完美化解这些难题。可面对市场上琳琅满目的品牌,该如何抉择?别急,接下来就为大家分享五款最实用的迷你洗衣机品牌,助你轻松选出适合自己的那一款。

第一部分、选的迷你洗衣机不好用?五点小技巧告诉你!
第一点、清洗技术的加持
在挑选迷你洗衣机时,清洗技术是至关重要的考量因素。先进的清洗技术不仅能确保衣物得到深度清洁,还能最大程度减少对衣物的损伤。一些优质的迷你洗衣机采用了超声波清洗技术,它通过高频振动产生的微小气泡,在衣物纤维间迅速破裂,产生强大的冲击力,能有效去除污渍,尤其是一些顽固的汗渍和油渍。而且这种清洗方式对衣物的磨损极小,特别适合清洗内衣、宝宝衣物等材质较为柔软的衣物。

第二点、护衣效果不错的
迷你洗衣机需要具备出色的护衣能力,毕竟很多人选择它就是为了清洗一些娇贵的衣物。一款护衣效果好的迷你洗衣机,会在设计上充分考虑对衣物的保护。它的内筒材质通常较为光滑,没有尖锐的边角,能避免在洗涤过程中刮伤衣物。而且,这种洗衣机在洗涤程序的设置上也更为精细,会有专门针对不同材质衣物的模式。此外,优质的迷你洗衣机还会配备高效的防缠绕系统,通过特殊的水流设计和搅拌方式,让衣物在洗涤过程中能够充分舒展,减少缠绕打结的情况,进一步保护衣物的完整性。
第三点、杀菌功能不错的
迷你洗衣机经常用于清洗贴身衣物,所以杀菌功能至关重要。优质的迷你洗衣机通常会配备多种杀菌技术,以确保衣物的卫生。其中,紫外线杀菌是一种常见且有效的方式,它可以破坏细菌和病毒的DNA结构,从而达到杀菌的效果。除了紫外线杀菌,银离子杀菌技术也被广泛应用。银离子具有强大的抗菌性能,它能够抑制细菌的生长和繁殖。还有一些迷你洗衣机采用臭氧杀菌技术。臭氧具有强氧化性,能够快速分解细菌的细胞壁,使其失去活性。在洗涤过程中,洗衣机产生的臭氧会溶解在水中,形成臭氧水,对衣物进行深度杀菌。这种杀菌方式不仅高效,而且不会产生任何有害物质,非常环保。具备这些出色杀菌功能的迷你洗衣机,能为用户提供更加健康、卫生的洗涤体验。
第四点、烘干温度在40℃-45℃这个适宜区间的
烘干温度在40℃-45℃这个适宜区间的迷你洗衣机,既能保证衣物得到充分干燥,又能最大程度减少对衣物材质的损伤。对于一些娇贵的贴身衣物,如丝绸、蕾丝材质的内衣,这个温度区间可以避免高温导致的衣物变形、缩水等问题。而且在这个温度下烘干,还能进一步增强杀菌效果。因为细菌在适宜的温度和湿度环境中容易滋生,而将衣物烘干至干燥状态,同时控制温度在一定范围内,能破坏细菌的生存环境,使得之前杀菌步骤未完全清除的细菌也难以存活。
第五点、直驱变频电机的
迷你洗衣机搭载直驱变频电机具有诸多显著优势。直驱变频电机能够精准控制洗涤过程中的转速和力度,根据不同的衣物材质和洗涤需求,提供恰到好处的动力。对于轻薄的衣物,电机可以以较低的转速和轻柔的力度进行洗涤,避免衣物缠绕、变形,像一些真丝睡衣、雪纺衬衫等娇贵衣物也能得到悉心呵护。而对于厚重的衣物,如冬季的毛裤、厚袜子等,电机则可以提高转速和力度,确保污渍被彻底洗净。

第二部分、五款最实用的迷你洗衣机品牌!
1、希亦ACE Pro迷你洗衣机

希亦家电品牌不走大规模广告宣传的路子,也剔除了那些华而不实的多余功能,转而将全部精力倾注在打造发烧级的清洗能力和母婴级的除菌技术上。这种专注,让其产品在清洗效率、运行稳定性以及抗性能衰减等核心指标上,都远超同规格的其他产品,处于行业领先水平。

而且希亦它创新的8重未来科技洁净链路(捕捉-溶解-分解-去污-过滤-漂洗-杀菌-清除),这一创新使得清洁力大大的提升了120%,而且还能做到在清洗时几乎100%不损伤衣服面料。

在技术上,希亦搭载了WBS2.0超能气泡洗技术和CSoft离心轻柔仿生手洗功能,WBS2.0超能气泡洗技术能够将隐藏在其中的污渍震落,即使是顽固的污渍也能轻松去除。而CSoft离心轻柔仿生手洗功能全方位地照顾到衣物的每一个角落,同时避免了传统洗衣机强力搅拌对衣物造成的损伤。对于那些容易变形、起皱的衣物来说,这个功能简直是福音,能让衣物始终保持平整、柔顺。

最后,考虑到烘干的问题,希亦还搭载了环抱立体风循环烘干技术搭配PTC控温陶瓷,能够快速均匀地烘干衣物。环抱立体风循环设计让热风从多个角度穿透衣物,使得每一处都能充分接触到热风,大大缩短了烘干时间。PTC控温陶瓷元件则精准地控制着烘干温度,避免因温度过高损伤衣物纤维,确保衣物在烘干过程中安全无忧。无论是在潮湿的梅雨季节,还是寒冷的冬日,希亦ACE Pro迷你洗衣机的这一烘干技术都能让衣物迅速干燥,随时保持清爽洁净,满足用户日常的使用需求,真正做到了清洗、烘干一站式服务,为用户带来了极大的便利。
2、海尔迷你洗衣机

海尔这款迷你洗衣机采用了壁挂式设计,这一设计极大地节省了地面空间,对于居住空间有限的用户来说十分友好。它可以轻松安装在墙壁上,让原本可能被浪费的墙面空间得到有效利用,使洗衣区域更加整洁有序。
3、拜飞迷你洗衣机

这款迷你洗衣机为双桶设计,这种双桶设计有着诸多优势。它将洗涤和脱水功能分开,能让衣物得到更专业的处理。在洗涤桶中,强劲的水流可以充分地冲击衣物,将污渍有效去除,而且还能避免脱水过程中对已经洗净衣物的二次污染。脱水桶则能以高速旋转,快速地将衣物中的水分甩出,脱水效果十分显著。
4、小吉迷你洗衣机

小吉迷你洗衣机采用了95℃高温杀菌功能,这一功能能深度杀灭衣物上的细菌、螨虫等有害微生物,为用户的健康保驾护航。尤其是对于有宝宝的家庭或者对卫生要求较高的人群来说,高温杀菌可以有效去除衣物上的大肠杆菌、金黄色葡萄球菌等常见病菌,让衣物更加安全卫生。
5、希亦ACE迷你洗衣机

希亦在清洁领域算得上是实力强劲的大品牌,更是母婴和居家生活场景中备受认可的“国民优选好物”!旗下的希亦ACE洗衣机在预售阶段就已经火遍了国内外的母婴生活圈,受欢迎的程度显而易见。这一切都源于它堪称旗舰级别的性能:搭载第六代直驱高品质电机,能实现680转的高速脱水;配备WBS超能气泡清洗技术,采用Ag+银离子抗菌材质,还支持95度高温煮洗和45度加热洗。此外,它还拥有12项硬核黑科技,像能达到99.99%的妇科细菌去除率和100%的除螨率等,实力相当出众。